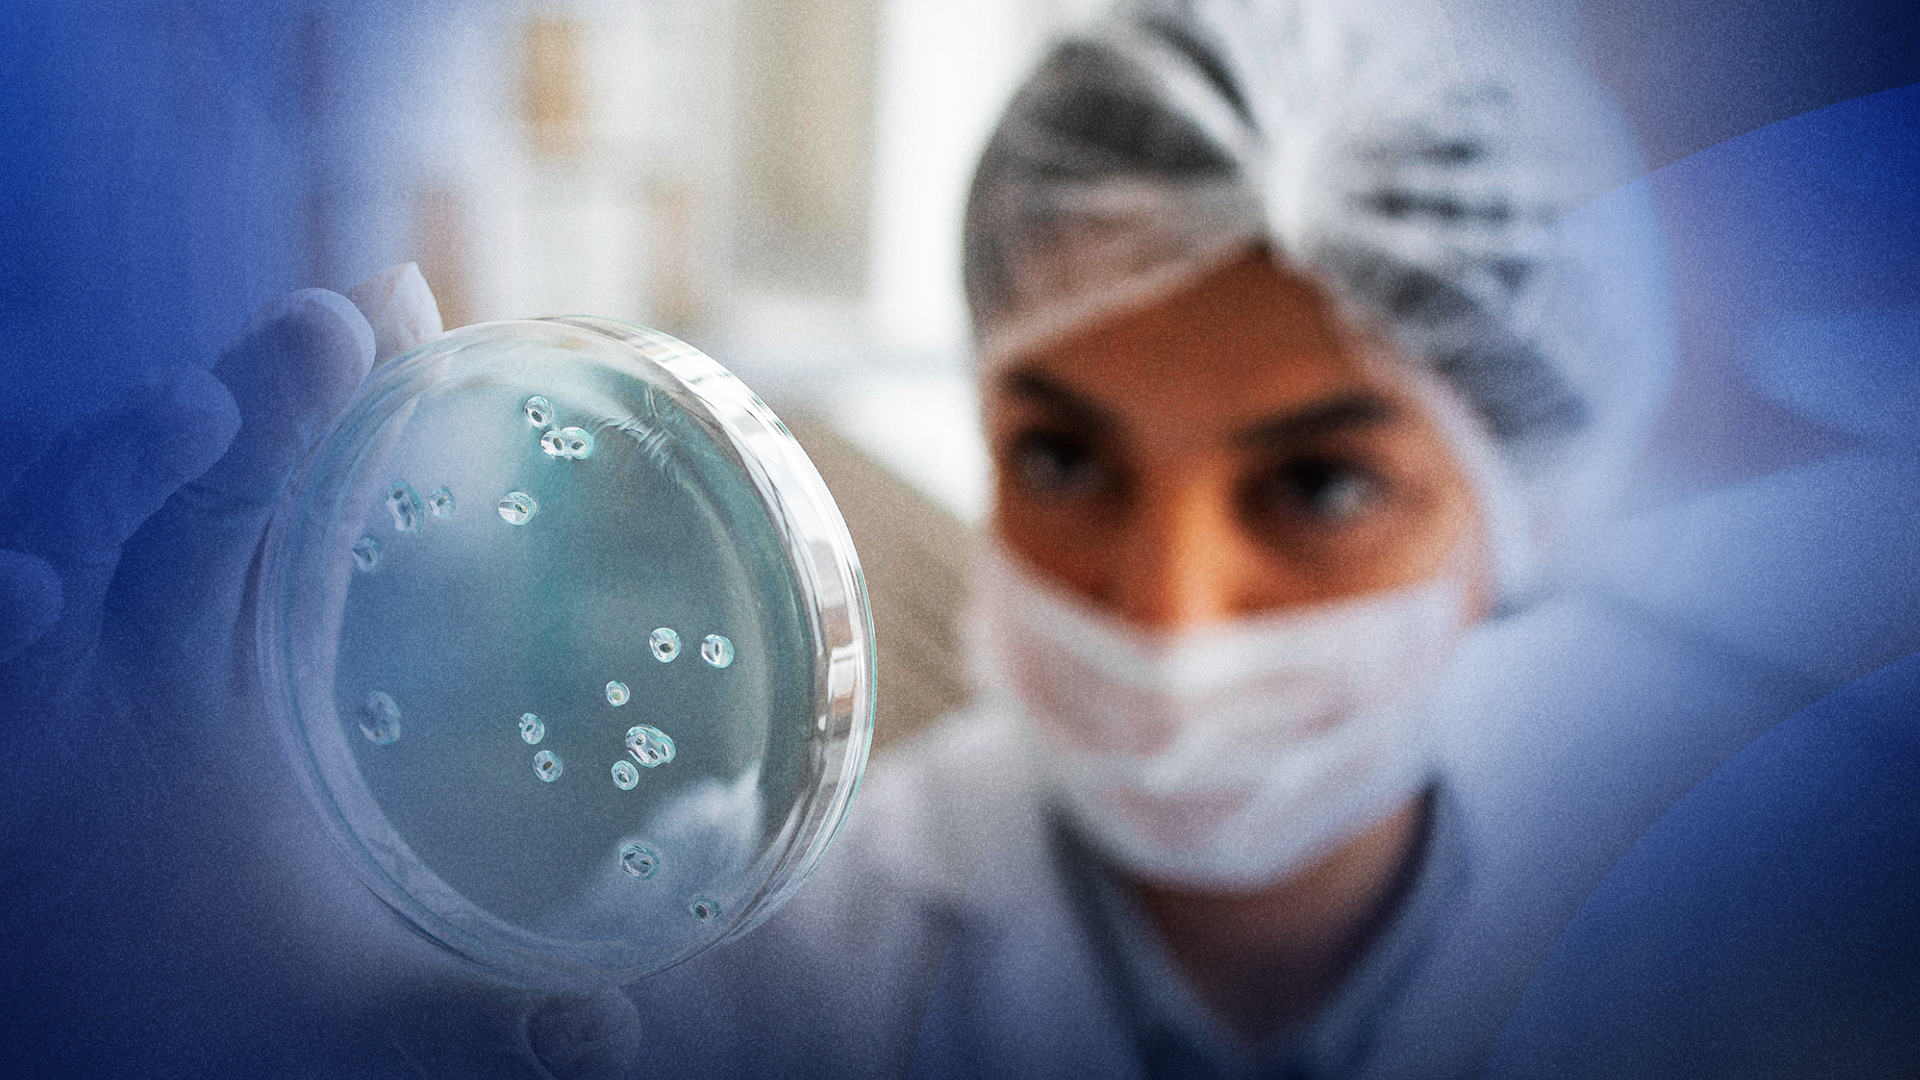

O penúltimo dia do XXII Congresso Brasileiro de Oncologia Clínica, 19 de novembro, seguiu apresentando os últimos avanços do conhecimento científico e da prática clínica contra diversos tipos de câncer, celebrando a ciência também em forma de premiações e abordando, ainda, a importância da espiritualidade no cuidado oncológico.
Antes das homenagens, ocorridas na Seção Plenária da SBOC, a presidente da Comissão Científica do evento, Dra. Clarissa Mathias coordenou as apresentações de dois renomados convidados: Dr. Don S. Sizon, professor de Medicina da Brown University e diretor da Oncologia do Hospital Rhode Island, nos Estados Unidos; e Dr. Max Mano, membro do Comitê de Tumores Mamários da SBOC.
À frente de uma palestra sobre o uso das redes sociais para o combate ao câncer, Dr. Sizon celebrou a presença da SBOC na Internet. “O alcance da SBOC nas redes sociais é tão grande que oncologistas e muitos outros profissionais ligados ao cuidado oncológico acessam seus conteúdos frequentemente”, contou. Para ele, “o desenvolvimento científico não pode prescindir do uso da Internet e das redes sociais em especial, sob pena de isolar-se e não dialogar com as demandas reais das populações”.
Já outro uso da Internet foi questionado nas discussões ocorridas logo em seguida e conduzidas por Dr. Max Mano: o acesso irrestrito a laudos e exames por parte de pacientes e o uso intensificado de aplicativos de troca de mensagens instantâneas com seus médicos. O oncologista e pesquisador apresentou, na ocasião, dados de um estudo seu sobre o assunto, recém-publicado na respeitada revista científica The Lancet.
“Quase metade dos oncologistas que participaram do estudo contou que os relatórios de patologia e radiologia acessíveis ao paciente tiveram impacto negativo na comunicação. Patologistas também relataram sentimentos contraditórios sobre os pacientes acessando relatórios disponibilizados online”, contou. “Para pacientes com câncer, a apreensão sobre o estado e o curso da doença pode afetar ainda mais o bem-estar e a qualidade de vida, e isso é agravado pelo acesso irrestrito concedido a eles por prestadores de cuidados de saúde”, alertou.
Espiritualidade
Ainda com foco no bem-estar do paciente oncológico em sua árdua jornada de enfrentamento do câncer, foi realizada a sessão especial Espiritualidade na Oncologia. Na ocasião, foram apresentados dados de um levantamento realizado pela SBOC sobre como oncologistas lidam com o tema, e que será transformado em um consenso da entidade em breve.
Foram ouvidos 130 oncologistas, entre associados SBOC e participantes do congresso. Deles, 96% consideram o tema espiritualidade relevante para ser objeto de um consenso sobre cuidado oncológico produzido pela SBOC, e 92% acreditam que a reflexão enriquece a relação médico-paciente. Apesar disso, apenas 20% disseram ter recebido alguma orientação sobre espiritualidades na formação médica.
“Diversos estudos comprovam que o paciente deseja ter essa interação com seu médico, sobre aquilo em que ele acredita e deposita sua fé, suas crenças, sua forma de expressar espiritualidade. Não se trata apenas de uma questão religiosa, mas de acolhimento”, defendeu Dra. Clarissa Mathias.
Participaram das reflexões, também, a diretora da SBOC Dra. Maria de Fátima Gaui e os também oncologistas Dr. Carlos Jose Coelho de Andrade, Dr. Rodolfo Gadia, Dr. Diego de Araújo Toloi e Dra. Sarah Ananda Gomes.
Gincanas SBOC
Após as apresentações, foi a vez de celebrar o conhecimento científico e a oncologia dando nome e prêmio a quem se destacou em seu campo de atuação, nas diferentes modalidades de premiação concedidas pela SBOC.
A começar pelas duas competições virtuais promovidas pela SBOC para testar o conhecimento de residentes e graduandos em medicina. Dr. Rodrigo Munhoz, vice-presidente da entidade, foi o incumbido de entregar os troféus aos ganhadores da VI Gincana Nacional da Oncologia para Residentes – que, como parte da premiação, foram trazidos ao Congresso SBOC 2021: Dra. Zenaide Silva de Souza, em primeiro lugar; Dra. Beatriz Mendes Awni, em segundo; e Dr. Carlos Diego Holanda Lopes, em terceiro, todos do Hospital Sírio-Libanês.
“É uma alegria para a SBOC contribuir com o trabalho desses valorosos profissionais ao estimulá-los a ampliar o conhecimento que já possuem em oncologia. A residência é uma época muita rica da nossa formação oncológica, e fazer parte da história desses três futuros oncologistas é muito gratificante”, comemorou Dr. Rodrigo Munhoz.
Em seguida foi a vez do também diretor da SBOC Dr. Rafael Kaliks entregar os prêmios aos vencedores da II Gincana Nacional da Oncologia para Acadêmicos. “A educação em oncologia clínica é uma das prioridades da SBOC, e essa é uma disciplina ainda muito fragmentada na graduação, e formalmente quase que inexistente. Fomentar esse interesse precoce nos futuros médicos brasileiros é uma honra para a SBOC, e vê-los premiados por isso é muito especial”, disse o oncologista.
Receberam as premiações pelas maiores pontuações na competição Emanuela Lando, do IMED de Passo Fundo (RS), em primeiro lugar; Vinícius Gonçalves de Souza, da Universidade Federal de Jataí (GO), em segundo; e Alexandre Santos Schalch, da Universidade de São Paulo (SP), em terceiro.
Prêmios SBOC 2021
Após o futuro da oncologia subir ao palco da Plenária SBOC, foi a vez daqueles que desenvolvem a prática oncológica serem premiados. A exemplo dos troféus das gincanas, os prêmios foram entregues por diretores da SBOC. A avaliação e a seleção dos premiados foram realizadas, de forma sigilosa, pela Comissão Avaliadora dos Prêmios SBOC, composta por todos os membros da atual Diretoria da entidade, da Comissão de Ética e do Conselho Fiscal.
O escolhido para receber o Prêmio Jovem Oncologista SBOC, reconhecimento a profissionais que tenham oferecido contribuições importantes para a área antes dos 40 anos de idade, foi Dr. Romualdo Barroso.
Coordenador de Pesquisa Translacional no Hospital Sírio-Libanês em Brasília (DF), orientador do Programa de Pós-graduação em Ciências da Saúde do Instituto Sírio-Libanês de Ensino e Pesquisa e professor voluntário da Faculdade de Medicina da Universidade de Brasília (UNB), Dr. Romualdo se emocionou ao falar do reconhecimento de seus pares e ao agradecer seus mestres e amigos.
“Ganhar esse prêmio na mesma sessão que leva o nome do Ronaldo Ribeiro é muito significativo. Ele é a pessoa que mais me influenciou na vida. Não posso deixar de agradecer algumas outras, como Daniel Saragiotto, o cara que fez a melhor residência que eu pude ter na minha vida; meus amigos Dr. Jorge Sabbaga, um grande mestre; meus mentores, minha família, Dr. Carlos Dzik, Max Mano… Meu muito obrigado.”
Em seguida, foi entregue o Prêmio Pesquisa Oncológica Translacional a Dr. Carlos Gil, Presidente do Instituto Oncoclínicas e Chief Medical Officer do Grupo Oncoclínicas, membro do Career Development and Fellowship Committee da International Association for the Research and Treatment of Lung Cancer (IALSC) e do International Affairs Committee do American Association for Cancer Research (AACR), diretor no Brasil da International Network for Cancer Treatment and Research (INCTR) e membro do Board da Americas Health Foundation (AHF).
O prêmio é dedicado a autores de publicações em periódicos científicos de relevância internacional reconhecidos por suas contribuições à medicina translacional com aplicação na oncologia clínica. “
O Dr. Carlos Gil é Oncologista Torácico com doutorado em Oncologia Experimental – Free University of Amsterdam, Coordenador de Pesquisa em Oncologia do Instituto D’Or de Pesquisa e Ensino (IDOR), membro do Career Development and Fellowship Committee da International Association for the Research and Treatment of Lung Cancer (IALSC), International Affairs Committee do American Association for Cancer Research (AACR), Diretor no Brasil da International Network for Cancer Treatment and Research (INCTR) e membro do Board da Americas Health Foundation (AHF).
“A pesquisa translacional é a racionalização da intuição. Não consigo pensar como médico nem como homem se não de uma forma translacional, e o maior legado disso tudo são os alunos que foram sendo formados nessa jornada”, disse o presidente eleito da SBOC para a gestão 2023-2025.
O Prêmio SBOC de Protagonismo Feminino na Oncologia foi concedido a Dra. Rachel Riechelmann, docente da Pós-graduação da Universidade de São Paulo (USP), presidente do Grupo Brasileiro de Tumores Gastrointestinais, conselheira da Sociedade Europeia de Tumores Neuroendócrinos e membro do Comitê Educacional da European Society of Medical Oncology (ESMO).
A premiação é um reconhecimento a oncologistas mulheres que tenham contribuído significativamente para apoiar o desenvolvimento profissional de suas colegas, promovendo um ambiente de equidade baseado em meritocracia. “Esse prêmio me deixou muito feliz porque é um reconhecimento de pares, de alunos, mestrandos, doutorandos, pessoas com quem trabalhei junto e que tive a oportunidade de colaborar com a carreira”, celebrou.
O ganhador do Prêmio Ronaldo Ribeiro de Carreira em Oncologia Clínica foi Dr. Antonio Carlos Buzaid, do alto dos seus 39 anos de carreira na área oncológica.
Diretor médico geral do Centro Oncológico Antônio Ermírio de Moraes da Beneficência Portuguesa de São Paulo e membro do comitê gestor do Centro de Oncologia do Hospital Israelita Albert Einstein, Dr. Buzaid é um dos grandes protagonistas da oncologia nacional no Brasil e no mundo, e recebeu a premiação, que leva o nome de outros dos mais reverenciados oncologistas clínicos brasileiros, por ter se destacado em, pelo menos, duas décadas de exercício da profissão, sendo reconhecido como liderança em suas áreas de atuação, entre cargos ou atividades importantes na especialidade oncológica.
“Primeiro, obrigado pelo honroso prêmio. Ronaldo era um oncologista com quem tive a oportunidade de interagir por muitos anos, mas, além disso, ele era um gentleman, uma das qualidades que eu considero bastante importantes. Espero que o futuro me permita continuar honrando esse award.”
Por fim, foi entregue o Prêmio SBOC de Ciência a Dr. Wagner José Fávaro, por conta da inovação científica demonstrada no trabalho apresentado no XXII Congresso Brasileiro de Oncologia Clínica. O pesquisador esteve à frente do desenvolvendo da primeira imunoterapia 100% brasileira dentro de uma universidade pública, a Universidade Estadual de Campinas (UNICAMP): um nanofármaco que já demonstrou ter grande potencial na redução de tumores localizados na bexiga e que acaba de ser patenteado. “Ver a produção científica nacional ser reconhecida é uma grande alegria, especialmente em tempos tão desafiadores”, celebrou.
“A ciência, mais do que nunca, tem fornecido as respostas de que tanto precisamos contra os males que nos assolam. Com as premiações entregues hoje, a SBOC reforça ainda mais o papel que o conhecimento científico exerce na prática oncológica e na sociedade como um todo”, orgulha-se a presidente da entidade e da Comissão Executiva do SBOC 2021, Dra. Clarissa Mathias.

Endereço
Avenida Paulista, 2073, Edifício Horsa II – Conjunto Nacional Conj. 1003, São Paulo/SP, 01311-300
Telefone
+55 (11) 3192-9284